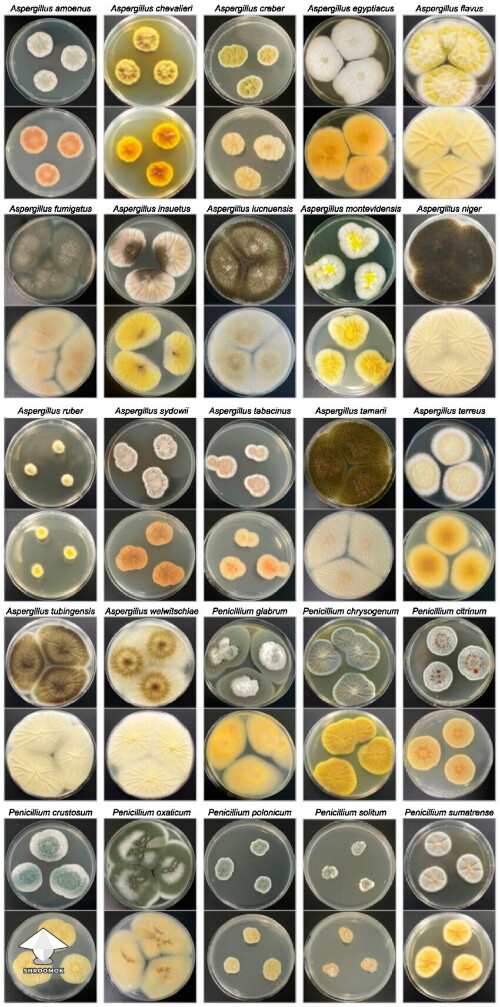
Colony morphology of Aspergillus and Penicillium species

Colony morphology of Aspergillus and Penicillium species
Colony morphology (top and reverse) of Aspergillus and Penicillium species isolated in this study after 5–10 days of incubation at 25°C in the dark on Czapek Yeast Extract Agar (CYA). Credit: Journal of Fungi (JoF) – "Occurrence and Diversity of Fungi and Their Mycotoxin Production in Common Edible and Medicinal Substances from China" – https://www.researchgate.net/publication/389730965_Occurrence_and_Diversity_of_Fungi_and_Their_Mycotoxin_Production_in_Common_Edible_and_Medicinal_Substances_from_China
Uploaded on

Comments
Add comment